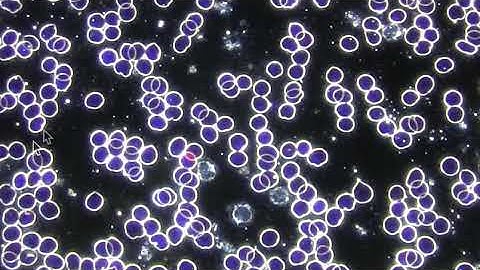
Purported Before & After Healy Blood Sample

⬇ DOWNLOAD NOW
Kalau muncul iklan pop-up, tutup lalu klik tombol kembali
Download lagu Healy Frequency Effect on Blood Cells After Just a 1 Hour Program secara gratis hanya untuk keperluan promosi. Dukung artis favorit kamu dengan membeli musik original di iTunes atau platform resmi lainnya.
 Healy's effect on Blood Cells after just 1 hour program !
Healy's effect on Blood Cells after just 1 hour program !
 Live Blood Cell Analysis Before & After 1hr Program with Healy Resonance Medical Biofeedback Device
Live Blood Cell Analysis Before & After 1hr Program with Healy Resonance Medical Biofeedback Device
Purported Before & After Healy Blood Sample
Purported Before & After Healy Blood Sample
 Label-free Live Cell Imaging: Activated T-Cell Killing Cancer Cell
Label-free Live Cell Imaging: Activated T-Cell Killing Cancer Cell
 The REAL truth about 432Hz
The REAL truth about 432Hz
 Healy Advanced Training with Christi Wong | Frequencies for the Brain & 5G Protection
Healy Advanced Training with Christi Wong | Frequencies for the Brain & 5G Protection
 Overcoming Self-Induced Terror Through Positive Thinking | Louise Hay
Overcoming Self-Induced Terror Through Positive Thinking | Louise Hay
 Parasite Cleanse Anyone? 🤮 #shorts
Parasite Cleanse Anyone? 🤮 #shorts